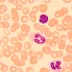

Mikroskop MAGUS Bio 250T je vysokovýkonný profesionálny biologický mikroskop určený pre laboratórne a výskumné účely v oblastiach ako je medicína, farmácia, kriminalistika, alebo poľnohospodárstvo. Tento prístroj je ideálny pre pozorovanie biologických vzoriek vo svetelnom poli a jeho funkcie môžu byť rozšírené o tmavé pole, polarizáciu a fázový kontrast (príslušenstvo nie je súčasťou balenia).
Rovinné achromatické objektívy s korekciou na nekonečno a širokouhlé okuláre poskytujú jasný, kontrastný obraz bez skreslenia. Základný rozsah zväčšenia 40x až 1000x možno navýšiť pomocou voliteľných okulárov alebo objektívov. Optický systém je modulárny, čo umožňuje jednoduché dovybavenie o ďalšie výskumné metódy.
Mikroskop je vybavený trinokulárnou hlavou s otočnými tubusmi o 360° a samostatným vertikálnym tubusom pre digitálny fotoaparát (nie je súčasťou). Vďaka dioptrickému nastaveniu ľavého tubusu a ergonomickému sklonu hlavice 30° je práca s mikroskopom pohodlná aj pri dlhodobom používaní.
30W halogénová žiarovka s možnosťou nastavenia jasu zabezpečuje intenzívne a rovnomerné osvetlenie, ktoré je vhodné pre rôzne pozorovacie metódy. Köhlerovo osvetlenie je možné vďaka vycentrovanému Abbeho kondenzoru s aperturnou a poľnou clonou, ktorý je výškovo nastaviteľný. Špeciálny slot v kondenzore umožňuje inštaláciu posuvníkov pre tmavé pole alebo fázový kontrast.
Mikroskop je ďalej vybavený mechanickým dvojvrstvovým stolíkom bez polohovacieho stojanu pre maximálnu ergonómiu, s možnosťou jemného a hrubého zaostrenia. Koaxiálny zaostrovací mechanizmus ponúka presné jemné zaostrenie (0,002 mm), aretačný gombík a nastavenie tuhosti hrubého zaostrenia, čo zvyšuje komfort pri dlhodobej práci.
Obsah balenia:
-
Základňa mikroskopu s napájaním a osvetlením
-
Trinokulárna hlava otočná o 360°
-
Rovinné achromatické objektívy s korekciou na nekonečno:
-
Širokouhlé okuláre 10x/22 mm s dlhým očným reliéfom (2 ks)
-
Očnice (2 ks)
-
Abbeho kondenzor N.A. 1,25 s výškovým nastavením, aperturnou a poľnou clonou, slotom pre posuvníky
-
Filtre: modrý, zelený, žltý
-
Adaptér pre fotoaparát s držiakom C-mount
-
Lahvička s imerzním olejom
-
Sieťový napájací kábel
-
Protiprachový kryt

Převodem
Na fakturu
Dobírka
Převodem
Na fakturu
Dobírka